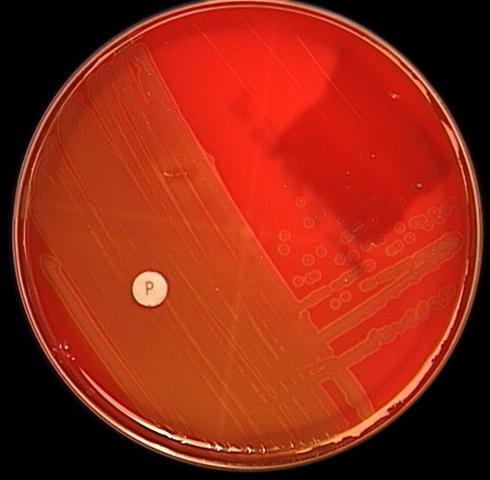

![]()
Created by
Paul A. Gulig, Ph.D.
Department of Molecular Genetics and Microbiology
with assistance from
David Brumbaugh
Here are the results of the Optochin (P disk) test. Some of the isolated colony type 2 from the blood agar plates was streaked heavily onto another blood agar plate, and a P disk containing Optochin was placed onto the streaked portion of the plate. The plate was incubated overnight at 37C.
What does this result mean?
What does this result mean?
A. It is viridans Streptococcus
B. It is Streptococcus pneumoniae
C. It is Streptococcus pyogenes
D. The result is ambiguous.